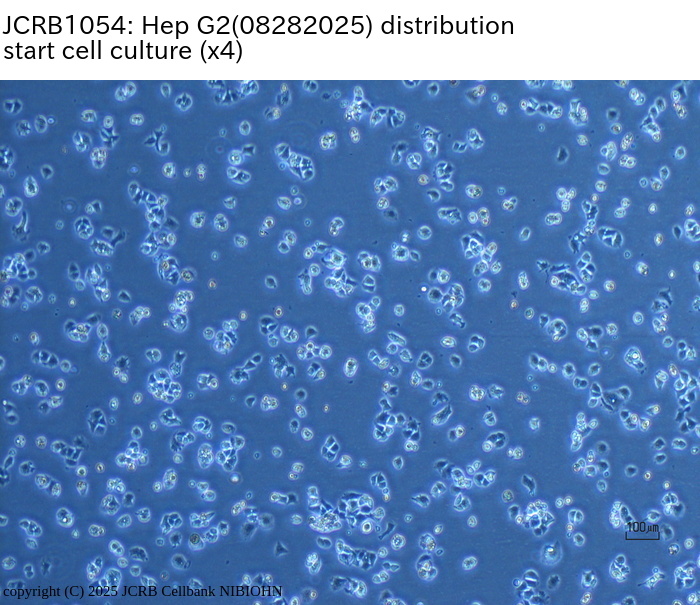

JCRB1054 Hep G2
Cell information
Cell type:general cells (View Pricing Information)
| JCRB No. | JCRB1054 | Cell Name | Hep G2 |
|---|---|---|---|
| Profile | Hepatoblastoma-derived (previously thought to be hepatocellular carcinoma-derived) cell line. | Other Name | HepG2 |
| Animal | human | Strain | |
| Genus | Homo | Species | sapiens |
| Sex | M | Age | 15 |
| Identity | available | Tissue for Primary Cancer | liver, gallbladder |
| Case history | liver cancer | Metastasis | |
| Tissue Metastasized | Genetics | ||
| Life Span | infinite | Crisis PDL | |
| Morphology | Character | Hepatoblastoma cell line. alpha-fetoprotein (+), HLA-A 02/2402. | |
| Classify | tumor | Established by | Knowless,B.B. |
| Registered by | Regulation for Distribution | ||
| Comment | Mycoplasmas were not detected three months after the decontamination. | Year | 2003 |
| Medium | Dulbecco's modified Eagle's medium with 10% fetal bovine serum. or GIT medium. | Methods for Passages | Cells harvested after treatment with 0.25% trypsin. |
| Cell Number on Passage | Race | ||
| CO2 Conc. | 5 % | Tissue Sampling | liver |
| Tissue Type | differentiated liver carcinoma |
| Detection of virus genome fragment by Real-time PCR | |||||||||
|---|---|---|---|---|---|---|---|---|---|
| Detected DNA Virus | tested | Detected RNA Virus | tested | ||||||
| CMV | - | parvoB19 | - | HCV | - | HTLV-1 | - | ||
| EBV | - | HBV | - | HIV-1 | - | HTLV-2 | - | ||
| HHV6 | - | HTLV-1 | - | HIV-2 | - | HAV | - | ||
| HHV7 | - | HTLV-2 | - |
-/negative. +/positive. nt/not tested. (positive (+) does not immediately mean the production of infectious viral particles.) |
|||||
| BKV | - | HIV-1 | - | ||||||
| JCV | - | HIV-2 | - | ||||||
| ADV | - | HPV18 | - | ||||||
| Notes | |||||||||
| Reference | |
|---|---|
| Pubmed id:9169468 | Regulation of human apolipoprotein A-I gene expression by gramoxone. Cuthbert C,Wang Z,Zhang X,Tam SP J Biol Chem. 1997 Jun 6;272(23):14954-60 |
| Pubmed id:8985401 | Formation of native hepatitis C virus glycoprotein complexes. Deleersnyder V,Pillez A,Wychowski C,Blight K,Xu J,Hahn YS,Rice CM,Dubuisson J J Virol. 1997 Jan;71(1):697-704 |
| Pubmed id:8971024 | Recombinant adenoviruses with large deletions generated by Cre-mediated excision exhibit different biological properties compared with first-generation vectors in vitro and in vivo. Lieber A,He CY,Kirillova I,Kay MA J Virol. 1996 Dec;70(12):8944-60 |
| Pubmed id:8943055 | Biochemical characterization and intracellular localization of the Menkes disease protein. Yamaguchi Y,Heiny ME,Suzuki M,Gitlin JD Proc Natl Acad Sci U S A. 1996 Nov 26;93(24):14030-5 |
| Pubmed id:8798649 | Activator protein 1 activity is involved in the regulation of the cell type-specific expression from the proximal promoter of the human profilaggrin gene. Jang SI,Steinert PM,Markova NG J Biol Chem. 1996 Sep 27;271(39):24105-14 |
| Pubmed id:8709260 | Adenovirus early region 4 34-kilodalton protein directs the nuclear localization of the early region 1B 55-kilodalton protein in primate cells. Goodrum FD,Shenk T,Ornelles DA J Virol. 1996 Sep;70(9):6323-35 |
| Pubmed id:8764004 | Hepatitis B virus HBx protein induces transcription factor AP-1 by activation of extracellular signal-regulated and c-Jun N-terminal mitogen-activated protein kinases. Benn J,Su F,Doria M,Schneider RJ J Virol. 1996 Aug;70(8):4978-85 |
| Pubmed id:8706128 | Alpha L beta 2 integrin/LFA-1 binding to ICAM-1 induced by cytohesin-1, a cytoplasmic regulatory molecule. Kolanus W,Nagel W,Schiller B,Zeitlmann L,Godar S,Stockinger H,Seed B Cell. 1996 Jul 26;86(2):233-42 |
| Pubmed id:8622980 | Fialuridine and its metabolites inhibit DNA polymerase gamma at sites of multiple adjacent analog incorporation, decrease mtDNA abundance, and cause mitochondrial structural defects in cultured hepatoblasts. Lewis W,Levine ES,Griniuviene B,Tankersley KO,Colacino JM,Sommadossi JP,Watanabe KA,Perrino FW Proc Natl Acad Sci U S A. 1996 Apr 16;93(8):3592-7 |
| Pubmed id:8626493 | Adenovirus E1A proteins regulate phosphoenolpyruvate carboxykinase gene transcription through multiple mechanisms. Klemm DJ,Colton LA,Ryan S,Routes JM J Biol Chem. 1996 Apr 5;271(14):8082-8 |
| Pubmed id:8626491 | The alpha-isoform of the CCAAT/enhancer-binding protein is required for mediating cAMP responsiveness of the phosphoenolpyruvate carboxykinase promoter in hepatoma cells. Roesler WJ,Crosson SM,Vinson C,McFie PJ J Biol Chem. 1996 Apr 5;271(14):8068-74 |
| Pubmed id:8626456 | Cellular internalization and degradation of antithrombin III-thrombin, heparin cofactor II-thrombin, and alpha 1-antitrypsin-trypsin complexes is mediated by the low density lipoprotein receptor-related protein. Kounnas MZ,Church FC,Argraves WS,Strickland DK J Biol Chem. 1996 Mar 15;271(11):6523-9 |
| Pubmed id:8626812 | The proximal promoter of the human transglutaminase 3 gene. Stratified squamous epithelial-specific expression in cultured cells is mediated by binding of Sp1 and ets transcription factors to a proximal promoter element. Lee JH,Jang SI,Yang JM,Markova NG,Steinert PM J Biol Chem. 1996 Feb 23;271(8):4561-8 |
| Pubmed id:8551615 | Hepatitis C virus glycoprotein folding: disulfide bond formation and association with calnexin. Dubuisson J,Rice CM J Virol. 1996 Feb;70(2):778-86 |
| Pubmed id:8380141 | Characterization of insulin-like growth factor II receptors in human small cell lung cancer cell lines. Schardt C,Rotsch M,Erbil C,Göke R,Richter G,Havemann K Exp Cell Res. 1993 Jan;204(1):22-9 |
| Pubmed id:2176219 | Differential regulation of hepatic triglyceride lipase and 3-hydroxy-3-methylglutaryl-CoA reductase gene expression in a human hepatoma cell line, HepG2. Busch SJ,Barnhart RL,Martin GA,Flanagan MA,Jackson RL J Biol Chem. 1990 Dec 25;265(36):22474-9 |
| Pubmed id:3034851 | Growth and hepatospecific gene expression of human hepatoma cells in a defined medium. Darlington GJ,Kelly JH,Buffone GJ In Vitro Cell Dev Biol. 1987 May;23(5):349-54 |
| Pubmed id:6248960 | Human hepatocellular carcinoma cell lines secrete the major plasma proteins and hepatitis B surface antigen. Knowles BB,Howe CC,Aden DP Science. 1980 Jul 25;209(4455):497-9 |
| Pubmed id:233137 | Controlled synthesis of HBsAg in a differentiated human liver carcinoma-derived cell line. Aden DP,Fogel A,Plotkin S,Damjanov I,Knowles BB Nature. 1979 Dec 6;282(5739):615-6 |
| Research results by users. Click! | |
|---|---|
| Pubmed id:34129097 |
Subcellular dynamics of estrogen-related receptors involved in transrepression through interactions with scaffold attachment factor B1. Tanida T,Matsuda KI,Uemura T,Yamaguchi T,Hashimoto T,Kawata M,Tanaka M Histochem Cell Biol. 2021 Sep;156(3):239-251 |
| Pubmed id:32851675 |
Novel metabolic system for lactic acid via LRPGC1/ERRγ signaling pathway. Tanida T,Matsuda KI,Tanaka M FASEB J. 2020 Oct;34(10):13239-13256 |
| Images |
|---|
                        |
| Movies |
|---|



|
LOT Information
Viability/Growth rate/Cell number are represented as actual values measured at lot presentation in JCRB, but are not guaranteed values. Additionally, the doubling time is a rough value measured during passages.- 04072011
- 07202010
- 11042009
- 02272009
- 07112007
- 05152006
- 11182004
- 08082003
- 07302003
- 05272013
- 04202017
- 07052018
- 08262020
- 04012022
- 20240206
- 04262024
- 08282025
| Cell No. | JCRB1054 | Cell Name | Hep G2 |
|---|---|---|---|
| LOT No. | 04072011 | Lot Specification | distribution |
| Medium | Dulbecco's modified Eagle's medium (1g/L glucose) with 10% fetal bovine serum (GIBCO Cat. # 10099) | Temperature | 37 C |
| Cell Density at Seeding | approx. 1 x 10^5 cells/mL | Methods for Passages | Cells were harvested after treatment with 0.25% trypsin and 0.02% EDTA. |
| Doubling Time | approx. 30 hrs. | Cell Number in Vial (cells/1ml) | 3.0 x 10^6 |
| Viability at cell freezing (%) | 98.7 | Antibiotics Used | free |
| Passage Number | Unknown (11 at bank) | PDL | |
| Sterility: MYCOPLASMA | - | Sterility: BACTERIA | - |
| Sterility: FUNGI | - | Isozyme Analysis | Confirmed as human by NP, G6PD (type B), MD. |
| Chromosome Mode | Chromosome Information | ||
| Surface Antigen | DNA Profile (STR) | ||
| Adhesion | Yes | Exoteric Gene | |
| Medium for Freezing | 10% DMSO, 20% FBS - DMEM | CO2 Conc. | 5% |
| Viability immediately after thawing (%) | Additional information |
| Cell No. | JCRB1054 | Cell Name | Hep G2 |
|---|---|---|---|
| LOT No. | 07202010 | Lot Specification | distribution |
| Medium | Dulbecco's modified Eagle's medium with 10% heat inactivated fetal bovine serum(SIGMA027K03911) | Temperature | 37 C |
| Cell Density at Seeding | 2.95-5.0x10^4 cells/sq.cm | Methods for Passages | Cells were harvested after treatment with 0.25% trypsin. |
| Doubling Time | NT | Cell Number in Vial (cells/1ml) | 1.22x10^6 |
| Viability at cell freezing (%) | 94.1 | Antibiotics Used | free |
| Passage Number | p10* | PDL | NT |
| Sterility: MYCOPLASMA | - | Sterility: BACTERIA | - |
| Sterility: FUNGI | - | Isozyme Analysis | NT |
| Chromosome Mode | NT | Chromosome Information | NT |
| Surface Antigen | NT | DNA Profile (STR) | D5S818:11,12 D13S317:9,13 D7S820:10 D16S539:12,13 VWA:17 TH01:9 AM:X,Y TPOX:8,9 CSF1PO:10,11 |
| Adhesion | Yes | Exoteric Gene | NT |
| Medium for Freezing | Cell Banker BLC-1(Nihon Zenyaku Industries) | CO2 Conc. | 5 % |
| Viability immediately after thawing (%) | 86.89 | Additional information |
| Images |
|---|
       |
| Cell No. | JCRB1054 | Cell Name | Hep G2 |
|---|---|---|---|
| LOT No. | 11042009 | Lot Specification | distribution |
| Medium | Dulbecco's modified Eagle's medium with 10% fetal bovine serum (GIBCO Cat. # 10099) | Temperature | 37 C |
| Cell Density at Seeding | 0.9 - 1.8 x 10^5 cells/ml, passage twice a week. | Methods for Passages | 0.25% trypsin and 0.02% EDTA |
| Doubling Time | approx. 1 day | Cell Number in Vial (cells/1ml) | 3.6 x 10^6 |
| Viability at cell freezing (%) | 88.3 | Antibiotics Used | free |
| Passage Number | Unknown (11 at bank) | PDL | |
| Sterility: MYCOPLASMA | - | Sterility: BACTERIA | - |
| Sterility: FUNGI | - | Isozyme Analysis | Confirmed as human by NP, G6PD (type B), MD. |
| Chromosome Mode | Chromosome Information | ||
| Surface Antigen | DNA Profile (STR) | ||
| Adhesion | Yes | Exoteric Gene | |
| Medium for Freezing | 10% DMSO, 20% FBS - DMEM | CO2 Conc. | 5% |
| Viability immediately after thawing (%) | Additional information |
| Cell No. | JCRB1054 | Cell Name | |
|---|---|---|---|
| LOT No. | 02272009 | Lot Specification | distribution |
| Medium | Dulbecco's modified Eagle's medium with 10% fetal bovine serum (GIBCO Cat. # 10099, Lot 484375) | Temperature | 37 C |
| Cell Density at Seeding | approx. 2 x 10^5 cells/ml | Methods for Passages | 0.25% trypsin and 0.02% EDTA. Passage twice a week. |
| Doubling Time | approx. 1 day | Cell Number in Vial (cells/1ml) | 3.6 x 10^6 |
| Viability at cell freezing (%) | 97.3 | Antibiotics Used | free |
| Passage Number | Unknown (11 at bank) | PDL | |
| Sterility: MYCOPLASMA | - | Sterility: BACTERIA | - |
| Sterility: FUNGI | - | Isozyme Analysis | Confirmed as human by NP, G6PD (type B), MD. |
| Chromosome Mode | Chromosome Information | ||
| Surface Antigen | DNA Profile (STR) | ||
| Adhesion | Yes | Exoteric Gene | |
| Medium for Freezing | 10% DMSO, 20% FBS -DMEM | CO2 Conc. | 5% |
| Viability immediately after thawing (%) | Additional information |
| Cell No. | JCRB1054 | Cell Name | |
|---|---|---|---|
| LOT No. | 07112007 | Lot Specification | distribution |
| Medium | Dulbecco's modified Eagle's medium with 10% fetal bovine serum (FBS lot; GIBCO 484375) | Temperature | 37 C |
| Cell Density at Seeding | 1.5 x 10^5 cells/ml (passage twice a week) | Methods for Passages | 0.25% trypsin and 0.02% EDTA |
| Doubling Time | 21 hrs | Cell Number in Vial (cells/1ml) | 3.9 x 10^6 |
| Viability at cell freezing (%) | 97 | Antibiotics Used | free |
| Passage Number | Unknown (11 at bank) | PDL | |
| Sterility: MYCOPLASMA | - | Sterility: BACTERIA | - |
| Sterility: FUNGI | - | Isozyme Analysis | Confirmed as human by NP, G6PD (type B), AST, LD. |
| Chromosome Mode | Chromosome Information | ||
| Surface Antigen | DNA Profile (STR) | ||
| Adhesion | Yes | Exoteric Gene | |
| Medium for Freezing | 10% DMSO, 20% FBS - DMEM | CO2 Conc. | 5% |
| Viability immediately after thawing (%) | Additional information |
| Cell No. | JCRB1054 | Cell Name | |
|---|---|---|---|
| LOT No. | 05152006 | Lot Specification | distribution |
| Medium | Dulbecco's modified Eagle's medium with 10% fetal bovine serum (FBS lot; GIBCO 4218333S) | Temperature | 37 C |
| Cell Density at Seeding | 0.6 - 2 x 10^5 cells/ml | Methods for Passages | 0.25% trypsin and 0.02% EDTA |
| Doubling Time | approx. 1 day | Cell Number in Vial (cells/1ml) | 3.6 x 10^6 |
| Viability at cell freezing (%) | 98.1 | Antibiotics Used | free |
| Passage Number | Unknown (11 at bank) | PDL | |
| Sterility: MYCOPLASMA | - | Sterility: BACTERIA | - |
| Sterility: FUNGI | - | Isozyme Analysis | |
| Chromosome Mode | Chromosome Information | ||
| Surface Antigen | DNA Profile (STR) | ||
| Adhesion | Yes | Exoteric Gene | |
| Medium for Freezing | 10% DMSO, 20% FBS - DMEM | CO2 Conc. | 5% |
| Viability immediately after thawing (%) | Additional information |
| Cell No. | JCRB1054 | Cell Name | Hep G2 |
|---|---|---|---|
| LOT No. | 11182004 | Lot Specification | distribution |
| Medium | Dulbecco's modified Eagle's medium with 10% fetal bovine serum (FBS lot; GIBCO3762782S) | Temperature | 37 C |
| Cell Density at Seeding | 2 - 4 x 10^5 cells/ml | Methods for Passages | 0.25% trypsin and 0.02% EDTA |
| Doubling Time | approx. 22 hrs | Cell Number in Vial (cells/1ml) | 5.6 x 10^6 |
| Viability at cell freezing (%) | 93 | Antibiotics Used | free |
| Passage Number | P12 at bank | PDL | |
| Sterility: MYCOPLASMA | - | Sterility: BACTERIA | - |
| Sterility: FUNGI | - | Isozyme Analysis | Confirmed as human by NP, G6PD (type B), MD. |
| Chromosome Mode | Chromosome Information | ||
| Surface Antigen | DNA Profile (STR) | ||
| Adhesion | Yes | Exoteric Gene | |
| Medium for Freezing | 10% DMSO, 20% FBS - DMEM | CO2 Conc. | 5% |
| Viability immediately after thawing (%) | Additional information |
| Cell No. | JCRB1054 | Cell Name | Hep G2 |
|---|---|---|---|
| LOT No. | 08082003 | Lot Specification | distribution |
| Medium | Dulbecco's modified Eagle's medium with 10% fetal calf serum (Intergen RB52305). | Temperature | 37 C |
| Cell Density at Seeding | 2-3 x 10^4 cells/sq.cm. | Methods for Passages | Cells are harvested after treatment with 0.25% typsin. Subculture once a 4-6 days and medium change every 3-4 days. |
| Doubling Time | NT | Cell Number in Vial (cells/1ml) | 3.2 x 10^6 |
| Viability at cell freezing (%) | 98.3 | Antibiotics Used | free |
| Passage Number | P10* | PDL | NT |
| Sterility: MYCOPLASMA | - | Sterility: BACTERIA | - |
| Sterility: FUNGI | - | Isozyme Analysis | G6PD(typeB), NP, LDH examined. Human not HeLa. |
| Chromosome Mode | NT | Chromosome Information | NT |
| Surface Antigen | NT | DNA Profile (STR) | |
| Adhesion | Yes | Exoteric Gene | NT |
| Medium for Freezing | Culture medium with 5% DMSO. | CO2 Conc. | 5 % |
| Viability immediately after thawing (%) | Additional information |
| Images |
|---|
       |
| Cell No. | JCRB1054 | Cell Name | Hep G2 |
|---|---|---|---|
| LOT No. | 07302003 | Lot Specification | distribution |
| Medium | Dulbecco's modified Eagle's medium with 10% fetal calf serum (Intergen RB52305). | Temperature | 37 C |
| Cell Density at Seeding | 2-4 x 10^4 cells/sq.cm. | Methods for Passages | Cells harvested after treatment with 0.25% trypsin for 10 min. at room temperature. Subculture every 4-6 days and medium change every 3-4 days. |
| Doubling Time | NT | Cell Number in Vial (cells/1ml) | 7.1 x 10^6 |
| Viability at cell freezing (%) | 97.5 | Antibiotics Used | free |
| Passage Number | P9* | PDL | NT |
| Sterility: MYCOPLASMA | - | Sterility: BACTERIA | - |
| Sterility: FUNGI | - | Isozyme Analysis | G6PD(typeB), NP, LDH examined. Human not HeLa. |
| Chromosome Mode | NT | Chromosome Information | NT |
| Surface Antigen | NT | DNA Profile (STR) | |
| Adhesion | Yes | Exoteric Gene | NT |
| Medium for Freezing | Culture medium containing 5% DMSO. | CO2 Conc. | 5 % |
| Viability immediately after thawing (%) | Additional information |
| Images |
|---|
      |
| Cell No. | JCRB1054 | Cell Name | Hep G2 |
|---|---|---|---|
| LOT No. | 05272013 | Lot Specification | distribution |
| Medium | Dulbecco's modified Eagle's medium (1 g/L glucose) with 10% fetal bovine serum. (FBS: GIBCO Cat. #10099) | Temperature | 37 C |
| Cell Density at Seeding | 1.4 x 10^5 cells/mL | Methods for Passages | Cells harvested after treatment with 0.25% trypsin. |
| Doubling Time | Cell Number in Vial (cells/1ml) | 1.2 x 10^7 | |
| Viability at cell freezing (%) | Antibiotics Used | free | |
| Passage Number | Unknown (12 at bank) | PDL | |
| Sterility: MYCOPLASMA | - | Sterility: BACTERIA | - |
| Sterility: FUNGI | - | Isozyme Analysis | G6PD(typeB),NP,LDH were examined. Human,not HeLa |
| Chromosome Mode | Chromosome Information | ||
| Surface Antigen | DNA Profile (STR) | ||
| Adhesion | Yes | Exoteric Gene | |
| Medium for Freezing | 10% DMSO, 20% FBS - DMEM | CO2 Conc. | 5% |
| Viability immediately after thawing (%) | 97.4 | Additional information |
| Cell No. | JCRB1054 | Cell Name | Hep G2 |
|---|---|---|---|
| LOT No. | 04202017 | Lot Specification | distribution |
| Medium | Dulbecco's modified Eagle's medium with 10% fetal bovine serum (FBS; Sigma Cat. # 172012) | Temperature | 37 C |
| Cell Density at Seeding | approx. 1.5 x 10^5 cells/mL | Methods for Passages | Cells were harvested after treatment with 0.25% trypsin and 0.02% EDTA. |
| Doubling Time | approx. 30 hrs. | Cell Number in Vial (cells/1ml) | 2.5 x 10^6 |
| Viability at cell freezing (%) | 90.1 | Antibiotics Used | free |
| Passage Number | Unknown (11 at bank) | PDL | |
| Sterility: MYCOPLASMA | - | Sterility: BACTERIA | - |
| Sterility: FUNGI | - | Isozyme Analysis | |
| Chromosome Mode | Chromosome Information | ||
| Surface Antigen | DNA Profile (STR) | ||
| Adhesion | Yes | Exoteric Gene | |
| Medium for Freezing | 10% DMSO, 20% FBS - DMEM | CO2 Conc. | 5% |
| Viability immediately after thawing (%) | 90.1 | Additional information |
| Cell No. | JCRB1054 | Cell Name | Hep G2 |
|---|---|---|---|
| LOT No. | 07052018 | Lot Specification | distribution |
| Medium | Dubecco's modified Eagle's medium with 10% fetal bovine serum (FBS; Sigma Cat. # 172012) | Temperature | 37 C |
| Cell Density at Seeding | 0.8 - 3.1 x 10^5 cells/mL | Methods for Passages | Cells were harvested after treatment with 0.25% trypsin and 0.02% EDTA. Pssage twice a week. |
| Doubling Time | approx. 20 hrs. | Cell Number in Vial (cells/1ml) | 4.2 x 10^6 |
| Viability at cell freezing (%) | 94.6 | Antibiotics Used | free |
| Passage Number | Unknown (11 at bank) | PDL | |
| Sterility: MYCOPLASMA | - | Sterility: BACTERIA | - |
| Sterility: FUNGI | - | Isozyme Analysis | |
| Chromosome Mode | Chromosome Information | ||
| Surface Antigen | DNA Profile (STR) | ||
| Adhesion | Yes | Exoteric Gene | |
| Medium for Freezing | 10% DMSO, 20% FBS - DMEM | CO2 Conc. | 5% |
| Viability immediately after thawing (%) | 83.4 | Additional information |
| Cell No. | JCRB1054 | Cell Name | Hep G2 |
|---|---|---|---|
| LOT No. | 08262020 | Lot Specification | distribution |
| Medium | Dulbecco's modified Eagle's medium with 10% fetal bovine serum (FBS; Sigma Cat. # 172012) | Temperature | 37 C |
| Cell Density at Seeding | 1 - 2 x 10^5 cells/mL | Methods for Passages | Cells were harvested after treatment with 0.25% trypsin and 0.02% EDTA. |
| Doubling Time | approx. 1.5 days | Cell Number in Vial (cells/1ml) | 3.4 x 10^6 |
| Viability at cell freezing (%) | 98 | Antibiotics Used | free |
| Passage Number | Unknown (11 at bank) | PDL | |
| Sterility: MYCOPLASMA | - | Sterility: BACTERIA | - |
| Sterility: FUNGI | - | Isozyme Analysis | |
| Chromosome Mode | Chromosome Information | ||
| Surface Antigen | DNA Profile (STR) | ||
| Adhesion | Yes | Exoteric Gene | |
| Medium for Freezing | 10% DMSO, 20% FBS - DMEM | CO2 Conc. | 5% |
| Viability immediately after thawing (%) | 95 | Additional information |
| Cell No. | JCRB1054 | Cell Name | Hep G2 |
|---|---|---|---|
| LOT No. | 04012022 | Lot Specification | distribution |
| Medium | Dulbecco's modified Eagle's medium (low glucose) with 10% fetal bovine serum (FBS; Biowest Cat. # S1820-500) | Temperature | 37 C |
| Cell Density at Seeding | 1.3 - 2.5 x 10^5 cells/mL | Methods for Passages | Cells were harvested after treatment with 0.25% trypsin and 0.02% EDTA. |
| Doubling Time | approx. 1.5 day | Cell Number in Vial (cells/1ml) | 2.4 x 10^6 |
| Viability at cell freezing (%) | 98.9 | Antibiotics Used | free |
| Passage Number | Unknown (11 at bank) | PDL | |
| Sterility: MYCOPLASMA | - | Sterility: BACTERIA | - |
| Sterility: FUNGI | - | Isozyme Analysis | |
| Chromosome Mode | Chromosome Information | ||
| Surface Antigen | DNA Profile (STR) | ||
| Adhesion | Yes | Exoteric Gene | |
| Medium for Freezing | 5% DMSO, 20% FBS - DMEM | CO2 Conc. | 5% |
| Viability immediately after thawing (%) | 96.0 | Additional information |
| Cell No. | JCRB1054 | Cell Name | Hep G2 |
|---|---|---|---|
| LOT No. | 20240206 | Lot Specification | distribution |
| Medium | Dulbecco's modified Eagle's medium (Nacalai Tesque #08456-65 lot L3G3526) with 10% heat-inactivated fetal bovine serum (Nichirei Cat. # 174112, Lot 20M00K) | Temperature | 37 C |
| Cell Density at Seeding | 2-4x10^4 cells/sq.cm | Methods for Passages | Cells were harvested after treatment with 0.25% trypsin and 1mM EDTA. (Nacalai Tesque #335554-64 lot L3K4072) |
| Doubling Time | NT | Cell Number in Vial (cells/1ml) | 1.84x10^6 |
| Viability at cell freezing (%) | 98.3 | Antibiotics Used | free |
| Passage Number | p12* | PDL | NT |
| Sterility: MYCOPLASMA | - | Sterility: BACTERIA | - |
| Sterility: FUNGI | - | Isozyme Analysis | |
| Chromosome Mode | NT | Chromosome Information | NT |
| Surface Antigen | NT | DNA Profile (STR) | D5S818:11,12 D13S317:9,13 D7S820:10 D16S539:12,13 VWA:17 TH01:9 AM:X,Y TPOX:8,9 CSF1PO:10,11 |
| Adhesion | Yes | Exoteric Gene | NT |
| Medium for Freezing | BAMBANKER (LYMPHOTEC Inc.,CS-02-001, NIPPON Genetics Co., LTD) | CO2 Conc. | 5% |
| Viability immediately after thawing (%) | 96.7 | Additional information |
| Cell No. | JCRB1054 | Cell Name | Hep G2 |
|---|---|---|---|
| LOT No. | 04262024 | Lot Specification | distribution |
| Medium | Dulbecco's modified Eagle's medium with 10% fetal bovine serum (FBS; Nichirei Cat. # 174112, Lot 20M00K) | Temperature | 37 C |
| Cell Density at Seeding | 1.1 - 1.8 x 10^5 cells/mL | Methods for Passages | Cells were harvested after treatment with 0.25% trypsin and 0.02% EDTA. |
| Doubling Time | 25 - 40 hrs. | Cell Number in Vial (cells/1ml) | 2.8 x 10^6 |
| Viability at cell freezing (%) | 97.9 | Antibiotics Used | free |
| Passage Number | Unknown (11 at bank) | PDL | |
| Sterility: MYCOPLASMA | - | Sterility: BACTERIA | - |
| Sterility: FUNGI | - | Isozyme Analysis | |
| Chromosome Mode | Chromosome Information | ||
| Surface Antigen | DNA Profile (STR) | D5S818:11,12 D13S317:9,13 D7S820:10 D16S539:12,13 VWA:17 TH01:9 AM:X,Y TPOX:8,9 CSF1PO:10,11 |
|
| Adhesion | Yes | Exoteric Gene | |
| Medium for Freezing | 10% DMSO, 20% FBS - DMEM | CO2 Conc. | 5% |
| Viability immediately after thawing (%) | 95.3 | Additional information |
| Cell No. | JCRB1054 | Cell Name | Hep G2 |
|---|---|---|---|
| LOT No. | 08282025 | Lot Specification | distribution |
| Medium | Dulbecco's modified Eagle's medium (GIBCO:catalog No.11885-084) with 10% fetal bovine serum (Nichirei Cat. # 174112, Lot 20M00K). | Temperature | 37 C |
| Cell Density at Seeding | 1.7-1.8x10^4 cells/sq.cm | Methods for Passages | Cells were harvested after treatment with 0.25%trypsin(GIBCO) and 0.02% EDTA. |
| Doubling Time | NT | Cell Number in Vial (cells/1ml) | 1.9x10^6 |
| Viability at cell freezing (%) | 93 | Antibiotics Used | free |
| Passage Number | p10* | PDL | NT |
| Sterility: MYCOPLASMA | - | Sterility: BACTERIA | - |
| Sterility: FUNGI | - | Isozyme Analysis | |
| Chromosome Mode | NT | Chromosome Information | NT |
| Surface Antigen | NT | DNA Profile (STR) | D5S818:11,12 D13S317:9,13 D7S820:10 D16S539:12,13 VWA:17 TH01:9 AM:X,Y TPOX:8,9 CSF1PO:10,11 |
| Adhesion | Yes | Exoteric Gene | NT |
| Medium for Freezing | BAMBANKER (LYMPHOTEC Inc., CS-02-001, NIPPON Genetics Co., LTD) | CO2 Conc. | 5% |
| Viability immediately after thawing (%) | 96 | Additional information |
| Images |
|---|
|